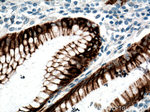
Cytokeratin 20 Antibody in Immunohistochemistry (Paraffin) (IHC (P))

Search
Proteintech
Cytokeratin 20 Monoclonal Antibody (4D10A4)
{{$productOrderCtrl.translations['antibody.pdp.commerceCard.promotion.promotions']}}
{{$productOrderCtrl.translations['antibody.pdp.commerceCard.promotion.viewpromo']}}
{{$productOrderCtrl.translations['antibody.pdp.commerceCard.promotion.promocode']}}: {{promo.promoCode}} {{promo.promoTitle}} {{promo.promoDescription}}. {{$productOrderCtrl.translations['antibody.pdp.commerceCard.promotion.learnmore']}}
产品信息
60183-1-IG
种属反应
已发表种属
宿主/亚型
分类
类型
克隆号
抗原
偶联物
形式
浓度
规格
纯化类型
保存液
内含物
保存条件
运输条件
产品详细信息
Immunogen sequence: MQNLNDRLA SYLEKVRTLE QSNSKLEVQI KQWYETNAPR AGRDYSAYYR QIEELRSQIK DAQLQNARCV LQIDNAKLAA EDFRLKYETE RGIRLTVEAD LQGLNKVFDD LTLHKTDLEI QIEELNKDLA LLKKEHQEEV DGLHKHLGNT VNVEVDAAPG LNLGVIMNEM RQKYEVMAQK NLQEAKEQFE RQTAVLQQQV TVNTEELKGT EVQLTELRRT SQSLEIELQS HLSMKESLEH TLEETKARYS SQLANLQSLL SSLEAQLMQI RSNMERQNNE YHILLDIKTR LEQEIATYRR LLEGEDVKTT EYQLSTLEER DIKKTRKIKT VVQEVVDGKV VSSEVKEVEE NI (74-424 aa encoded by BC031559)
靶标信息
The protein encoded by this gene is a member of the keratin family. The keratins are intermediate filament proteins responsible for the structural integrity of epithelial cells and are subdivided into cytokeratins and hair keratins. The type I cytokeratins consist of acidic proteins which are arranged in pairs of heterotypic keratin chains. This cytokeratin is a major cellular protein of mature enterocytes and goblet cells and is specifically expressed in the gastric and intestinal mucosa. The type I cytokeratin genes are clustered in a region of chromosome 17q12-q21.
仅用于科研。不用于诊断过程。未经明确授权不得转售。
生物信息学
蛋白别名: CK-20; cytokeratin 20; Cytokeratin-20; K20; keratin 20, type I; Keratin, type I cytoskeletal 20; Keratin-20; MGC35423; Protein IT; unnamed protein product
基因别名: CD20; CK-20; CK20; K20; KRT20; KRT21
UniProt ID: (Human) P35900
Entrez Gene ID: (Human) 54474